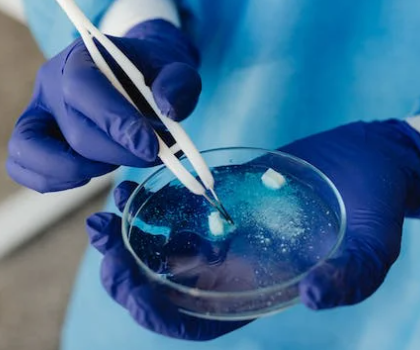

医学SCI润色价格是多少
大多数人都认为,作为一个医生,本职工作理应是看好病,治好病就行。科研不应该是科学家应该做的事情吗?确实,医生的临床工作繁重,每天完成一线工作后根本没有更多的精力进行科研,如果不是晋升压力,很多医生可能不会选择进行科研。纵观身边的临床小伙伴,无一不是忙到分身乏术。上班看门诊、做手术,做没有止境的临床工作;下班时间还要讨论课题、写论文,赶永远不够的科研成果;而各大节假日,更是各类学术会议扎堆。
医学英文SCI论文的撰写和刊登都不是一件容易的事情,如果英文水平不是很理想要怎么解决呢?可以选择润色机构帮忙,那么医学SCI润色价格是多少?意得辑的优质润色套餐,0.56元每词起的价格还是很美丽的,如果想要更专业一些,还可以选择科学深度编辑,润色价格为1.4元每词起。有了优质润色的辅助,能够让医生们的科研之路更轻松一些。那么,许多声音都在说,临床已经那么累了,医生真的还需要牺牲所有空余时间去搞科研吗?但除却精力有限外,医生真的不该搞科研吗?医学科研就应该是科学家的事情吗?其实,医生搞科研是很有必要的。
医生是临床问题的第一发现者
首先,对比于科学家,医生是临床问题的第一发现者。科研其实是一个发现问题,提出方法,解决问题的过程。如果抛开实际问题去做科研,那么医学研究就会变成空中楼阁,跟临床实际完全结合不上。举个例子,著名医学家张孝骞在他一生的行医生涯里,不断总结临床中遇到的问题,如对健康和患病时的胃分泌功能作了详细探讨,包括正常值、贫血、维生素A缺乏、热病等对胃酸的影响等等,为现代消化内科疾病的诊疗标准和方案做出了杰出贡献。
如果仅仅由科学家来进行医学研究,他们往往不能及时认识到真正的临床诊疗需求是什么,研究胃的分泌功能,可能是从分泌细胞、分泌过程的机制等等出发,而不是研究临床患者最常面临的疾病状态对胃酸的影响。
这样的研究虽然也是医学研究不可或缺的一部分,但往往和当下所急需解决的问题之间还隔着千山万水,不能立即作为临床诊疗的支持。因此,医生作为临床问题的第一发现者,对发现的问题着手进行研究,是能最快推动医学进步,为患者治疗带来希望的关键。
临床研究只能由医生来进行
其次,很多临床研究只能由医生来进行。有句话说得好,隔行如隔山。科学家在疾病诊疗上的认知远远比不过经验丰富的临床医生,而大多数临床研究需要通过判断和评估患者的疾病程度、治疗反应来作为结果,如果不是有经验的临床医生,对疾病进程的判断偏差会很大,根本无法得出客观科学的结论。
同时,如果要进行临床干预,患者在干预过程中很有可能出现治疗相关的不良反应,有时还可能危及生命,这也需要临床医生密切观察和随访,才能及时正确地发现与处理,避免出现无可挽回的后果。在临床研究中,年资高、经验多的医生往往是主导研究进行的不二人选。
再从更实际的角度想想,医生也要搞科研,就是因为缺做研究的高层次人才。很多时候不是医生该不该搞,而是医生不得不搞科研。如果理想情况下,每一个医生都能有一个科学研究团队,背后由科学家进行科研支持,医生从临床角度进行合作,那肯定不需要医生搞基础科研了,只需要医生从专业角度提供专业的意见和必要的支持。
那这样每个医生都会很开心,不断地去发掘有价值的临床问题。而现实问题就在于,目前推动医学的进步所需要的高层次研究人才远远不够。寥寥无几的科学家根本没有精力去帮助解决更多的临床问题,比如回答药物治疗的长期效果、疾病的进展与转归等等,这都需要时时呆在临床上的研究者来完成。
而临床医生普遍教育水平高,又是患者的第一责任人,不得不在无人解决这些迫切需要的临床问题时,承担搞科研的重要任务。如果医生不搞科研,医学在很多重要的时刻,都无法取得进步。
医生搞科研是实现自我价值
最后,说得崇高一点的,医生搞科研是实现自我价值的重要途径。有效的科研成果能帮助更多的医生更好地治疗患者,才能实现成为一代名医,从救千人变为救千万人的自我价值。
古往今来,中国医学史上的名医都是通过著书,总结自己的医治经验和理论,推动了医学的发展,才流芳百世的。换成如今,我们把科研成果写成一篇篇论文,和同道讨论、印证,成为疾病诊断、治疗的标准,也是一个著书的过程。
汤飞凡发现沙眼衣原体,顾方舟改良减毒脊髓灰质炎糖丸、试管婴儿之母张丽珠、呼吸重症专家钟南山……这些医生都是通过不断研究,试验新的医学手段,造福了无数患者,才实现了自我价值。
如果只是盲目地做临床工作,从不思考和发现更好地疾病诊疗手段,并通过研究去证明,医生的价值便狭隘为了医匠、医工了。
当然,我也理解有些医生可能会说不擅长科研,没有时间做科研。但是我们还是要支持医生应该搞科研,不能将科研都认为是科学家的事情,我们医生也是兼具研究能力和临床经验的最佳研究者,要鼓励和支持喜欢科研的医生去搞科研,为推动医学的发展进步贡献一份微薄之力。
除了为学界留下注脚,医生还是科学与公众间知识的载体。一项发布于2021年9月的文献计量分析显示,新冠肺炎话题下被引率前100的论文中,有53%为临床症状与治疗结果相关的内容。这些第一手医学观察经过多次传播去到其他跨领域的研究者和公众面前,对科学防疫不无积极作用。
不过身处信息过载的时代,读者大多追求速食易懂的科学,图文已然成为医学科普的好帮手。尤其是近年来许多期刊在投稿时规定提交的图文摘要,以其可视化的特点令读取信息更省事,许多配以图文摘要的研究传播表现也大有提升。
如果你也想用一张图讲清所研究的医学原理,为科学发表与传播加把劲,却又苦于时间精力上的限制,不妨将制图工作交给意得辑。逾二十年的学术出版经验令我们天然地关注技术细节,兼顾审美,更多详情欢迎扫码向意得辑客户顾问垂询。
参考文献:
Chan KIP, Ignacio KHD, Omar AT 2nd, Khu KJO. Top 100 Most Cited Neurologic and Neurosurgical Articles on COVID-19: A Bibliometric Analysis. World Neurosurg. 2022 Jan;157:e137-e147.doi: 10.1016/j.wneu.2021.09.118. Epub 2021 Oct 4. PMID: 34619402; PMCID: PMC8489273.

意得辑Editage专业SCI医学论文润色机构、拥有专业的医学论文润色团队,由资深医学领域专家级编辑组成,为您提供优质的医学论文、药学论文修改编辑、翻译、润色服务,专业覆盖220多个细分医学专业。
